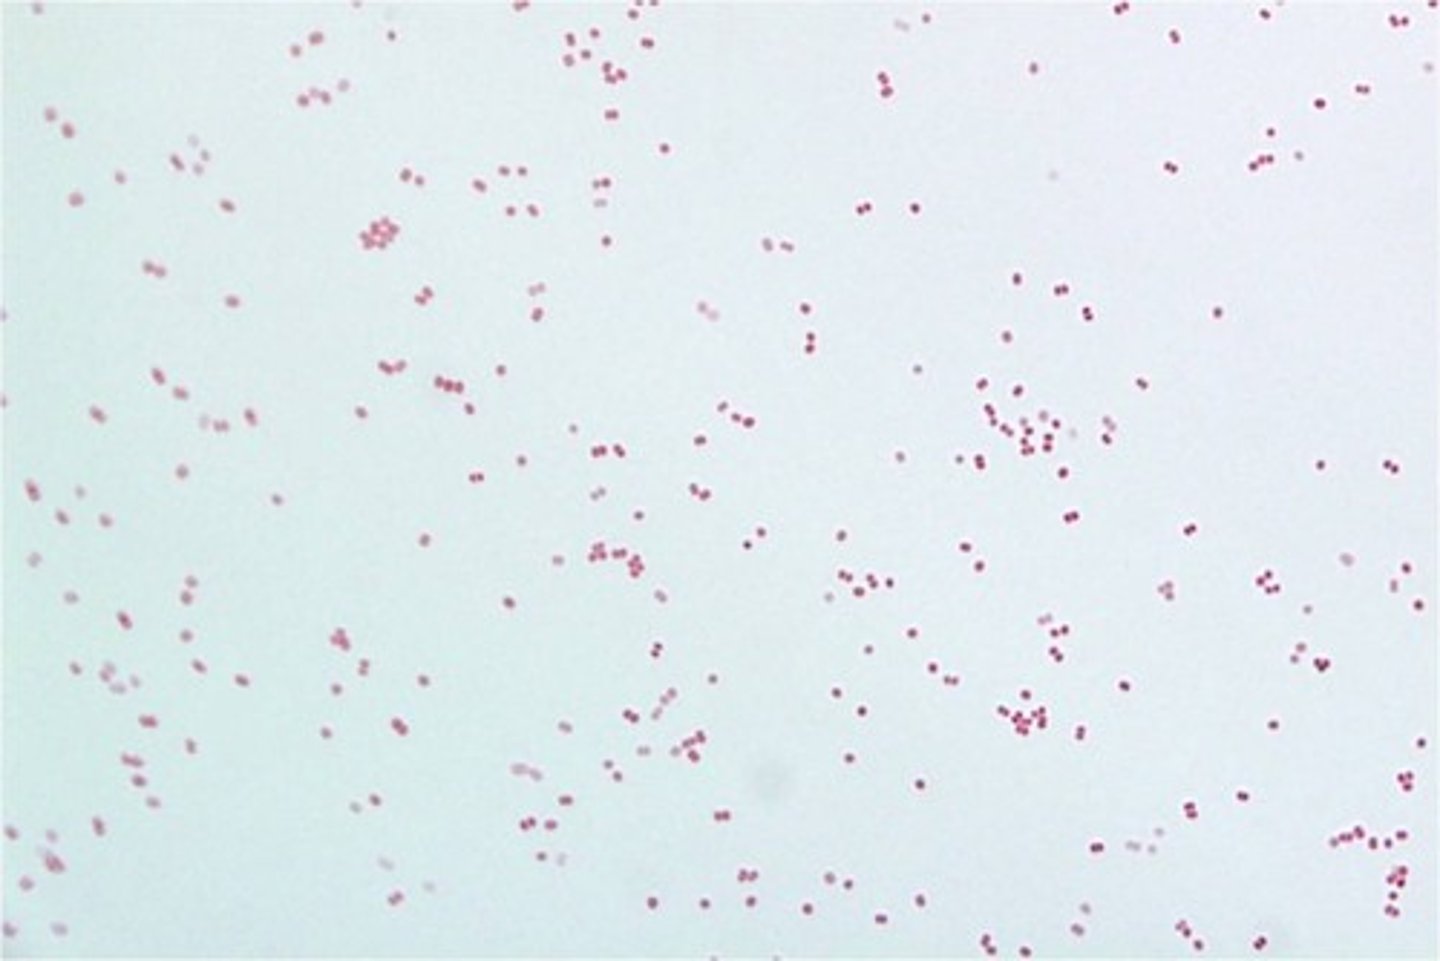
knowt flashcard image

Lab 4: Cell Morphology
1/15
There's no tags or description
Looks like no tags are added yet.
Name | Mastery | Learn | Test | Matching | Spaced | Call with Kai |
|---|
No analytics yet
Send a link to your students to track their progress
16 Terms
cocci
spherical or oval bacteria

Diplococcus
pair of cocci

Streptococcus
chain of cocci

Staphylococcus
cluster of cocci

Diplo bacillus
bacillus that occurs in pairs

streptobacillus
chain of rods

coccobacillus
short and plump rod shaped bacteria

Bacilli
Rod shaped bacteria
spiral
are bacteria that re all single with no special arrange ment

How could you tell the difference between coccus and coccobacillus ?
a coccobacillus will be longer and more oval but still rod shaped ( will always be longer than wide
Explain the difference between bacillus and Bacillus( italicized !)
Bacillus is describing cell morphology ; bacillus refers to a specific genus bacteria
Which genus of bacteria is the only genus discussed in the lab that produces palisades or snapping morphology?
Corynebacterium
Gram positive staphylococci

Gram-positive streptobacilli

gram negative spirillum

diplo cocci gram negative